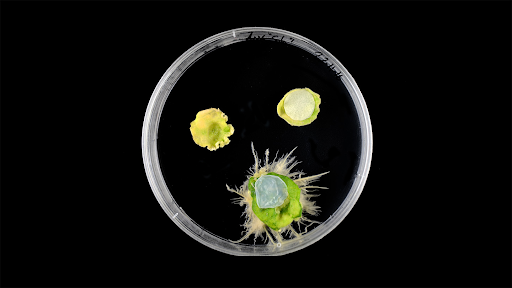

Bacterial cellulose patches accelerate plant wound healing and vegetative propagation, researchers report. In lab studies, patched wounds on Nicotiana and Arabidopsis healed 80% versus less than 20% for untreated cuts. The cellulose, loaded with bioactive plant hormones, triggers a protective genetic response, promoting faster tissue regeneration and root development effectively.
Copyright infringement not intended
Picture Courtesy: Sciencenews.org
Bacterial Band-Aids Speed Plant Healing and Regeneration
Researchers at the Centre for Research in Agricultural Genomics (CRAG) in Barcelona discovered that bacterial cellulose patches significantly accelerate wound healing and tissue regeneration in plants, according to a study published in Science Advances.
Botanist Núria Sánchez Coll initially tested bacterial cellulose patches on wounded plants to prevent infections.
Scientists made small cuts on leaves of two lab plants (Nicotiana benthamiana and Arabidopsis thaliana).
Patches were applied to half of the wounds, while the other half remained untreated.
After one week, 80% of patched wounds healed completely, compared to <20% of untreated wounds.
Microscopic analysis revealed healthy tissue in treated wounds, while untreated wounds showed dehydration and stress.
The team observed that bacterial cellulose patches boosted vegetative propagation (cloning via cuttings).
In petri dish experiments, cuttings treated with the patches developed roots and leaves faster than untreated cuttings or those treated with plant-derived cellulose.
Visual Evidence:A petri dish experiment showed a cutting treated with bacterial cellulose (bottom) developed roots faster than untreated (left) or plant-cellulose-treated (top right) cuttings. |
Produced by certain bacteria, bacterial cellulose is a natural polymer already used in human medicine for wound healing due to its biocompatibility, biodegradability, and high water retention.
The patches contain plant hormones (produced by the bacteria during synthesis), which remain bioactive even after sterilization. Researchers believe the dense cellulose matrix preserves these hormones.
Genetically, bacterial cellulose leads to a unique healing response: it activates infection-defense genes and suppresses wound-repair genes, indicating that plants assume cellulose as a foreign body, which results in a protective mechanism.
Must Read Articles:
KLEBSIELLA PNEUMONIAE BACTERIA
ANCIENT MICROORGANISMS IN EXTREME ENVIRONMENTS
Source:
|
PRACTICE QUESTION Q.Critically analyze alternative nutrient management practices (e.g., crop rotation, biofertilizers). Are they scalable for large-scale agriculture? 150 words |


© 2026 iasgyan. All right reserved